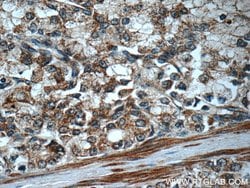

Learn More
FAS/CD95 Rabbit anti-Human, Polyclonal, Proteintech


Rabbit Polyclonal Antibody
Supplier: Proteintech Group Inc 130981AP150UL

Description
The molecular mass of native Fas is 38 kDa, the high molecular weight form (40-55 kDa) of Fas is due to glycosylation.
FAS (Fas, CD95, APO-1) is a 46 kDa transmembrane glycoprotein that functions as a cell death receptor of the TNFR (tumor necrosis factor receptor) superfamily. FAS also exists in a soluble form that weight approximately 26kDa. Stimulation of FAS results in aggregation of its intracellular FAS-associated death domains (FADD), formation of the death-inducing signaling complex (DISC) and activation of caspases. The auto-proteolytic processing of the caspases in the complex trigger a downstream cascade that leads to apoptosis. FAS has been shown to activate NF-kappaB, MAPK3/ERK1, MAPK8/JNK, and is involved in transducing the proliferating signals in normal diploid fibroblast and T cells. At least eight alternatively spliced transcript variants encoding seven distinct isoforms have been described. The isoforms lacking the transmembrane domain may negatively regulate the apoptosis mediated by the full-length isoform. The Fas/Fas ligand system has been shown to play a role in a number of human diseases such as AIDS, hepatitis and cancer. It is also assumed that induction of apoptosis through FAS ligand pathway is predomitly involved in anti-viral immune responses.Specifications
| FAS/CD95 | |
| Polyclonal | |
| Unconjugated | |
| FAS | |
| ALPS1A, APO 1, Apo 1 antigen, APT1, CD95, FAS, FAS1, FASLG receptor, FASTM, TNFRSF6 | |
| Rabbit | |
| Antigen Affinity Chromatography | |
| RUO | |
| 355 | |
| -20°C | |
| Liquid |
| Flow Cytometry, Immunohistochemistry (Paraffin), Immunoprecipitation, Western Blot | |
| 0.47 mg/mL | |
| PBS with 50% glycerol and 0.1% sodium azide; pH 7.3 | |
| P25445 | |
| FAS | |
| FAS/CD95 Fusion Protein Ag3718 | |
| 150 μL | |
| Primary | |
| Human | |
| Antibody | |
| IgG |
The Fisher Scientific Encompass Program offers items which are not part of our distribution portfolio. These products typically do not have pictures or detailed descriptions. However, we are committed to improving your shopping experience. Please use the form below to provide feedback related to the content on this product.